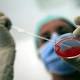
Eterologa: Italia ha violato anonimato donatori seme e ovuli - ANSA.it

ANSA.it | Eterologa: Italia ha violato anonimato donatori seme e ovuli ANSA.it l'Italia ha violato l'anonimato dei donatori di gameti nelle procedure per la fecondazione eterologa. Il Garante per la protezione dei dati personali, rispondendo ad una segnalazione dell'Associazione Luca Coscioni, ha infatti accertato che la ... Fecondazione: associazione Coscioni, Cnt viola anonimato donatori gametiArezzoWeb.it Ass. Coscioni: da Cnt gravissima violazione dati donatori gametiContattoNews.it Fecondazione eterologa, violato l'anonimato Il Garante ha accertato l'infrazioneSi24 - Il vostro sito quotidiano ANSA Valle d'Aosta -Radio Radicale -Osservatorio Malattie Rare tutte le notizie (10) » |
